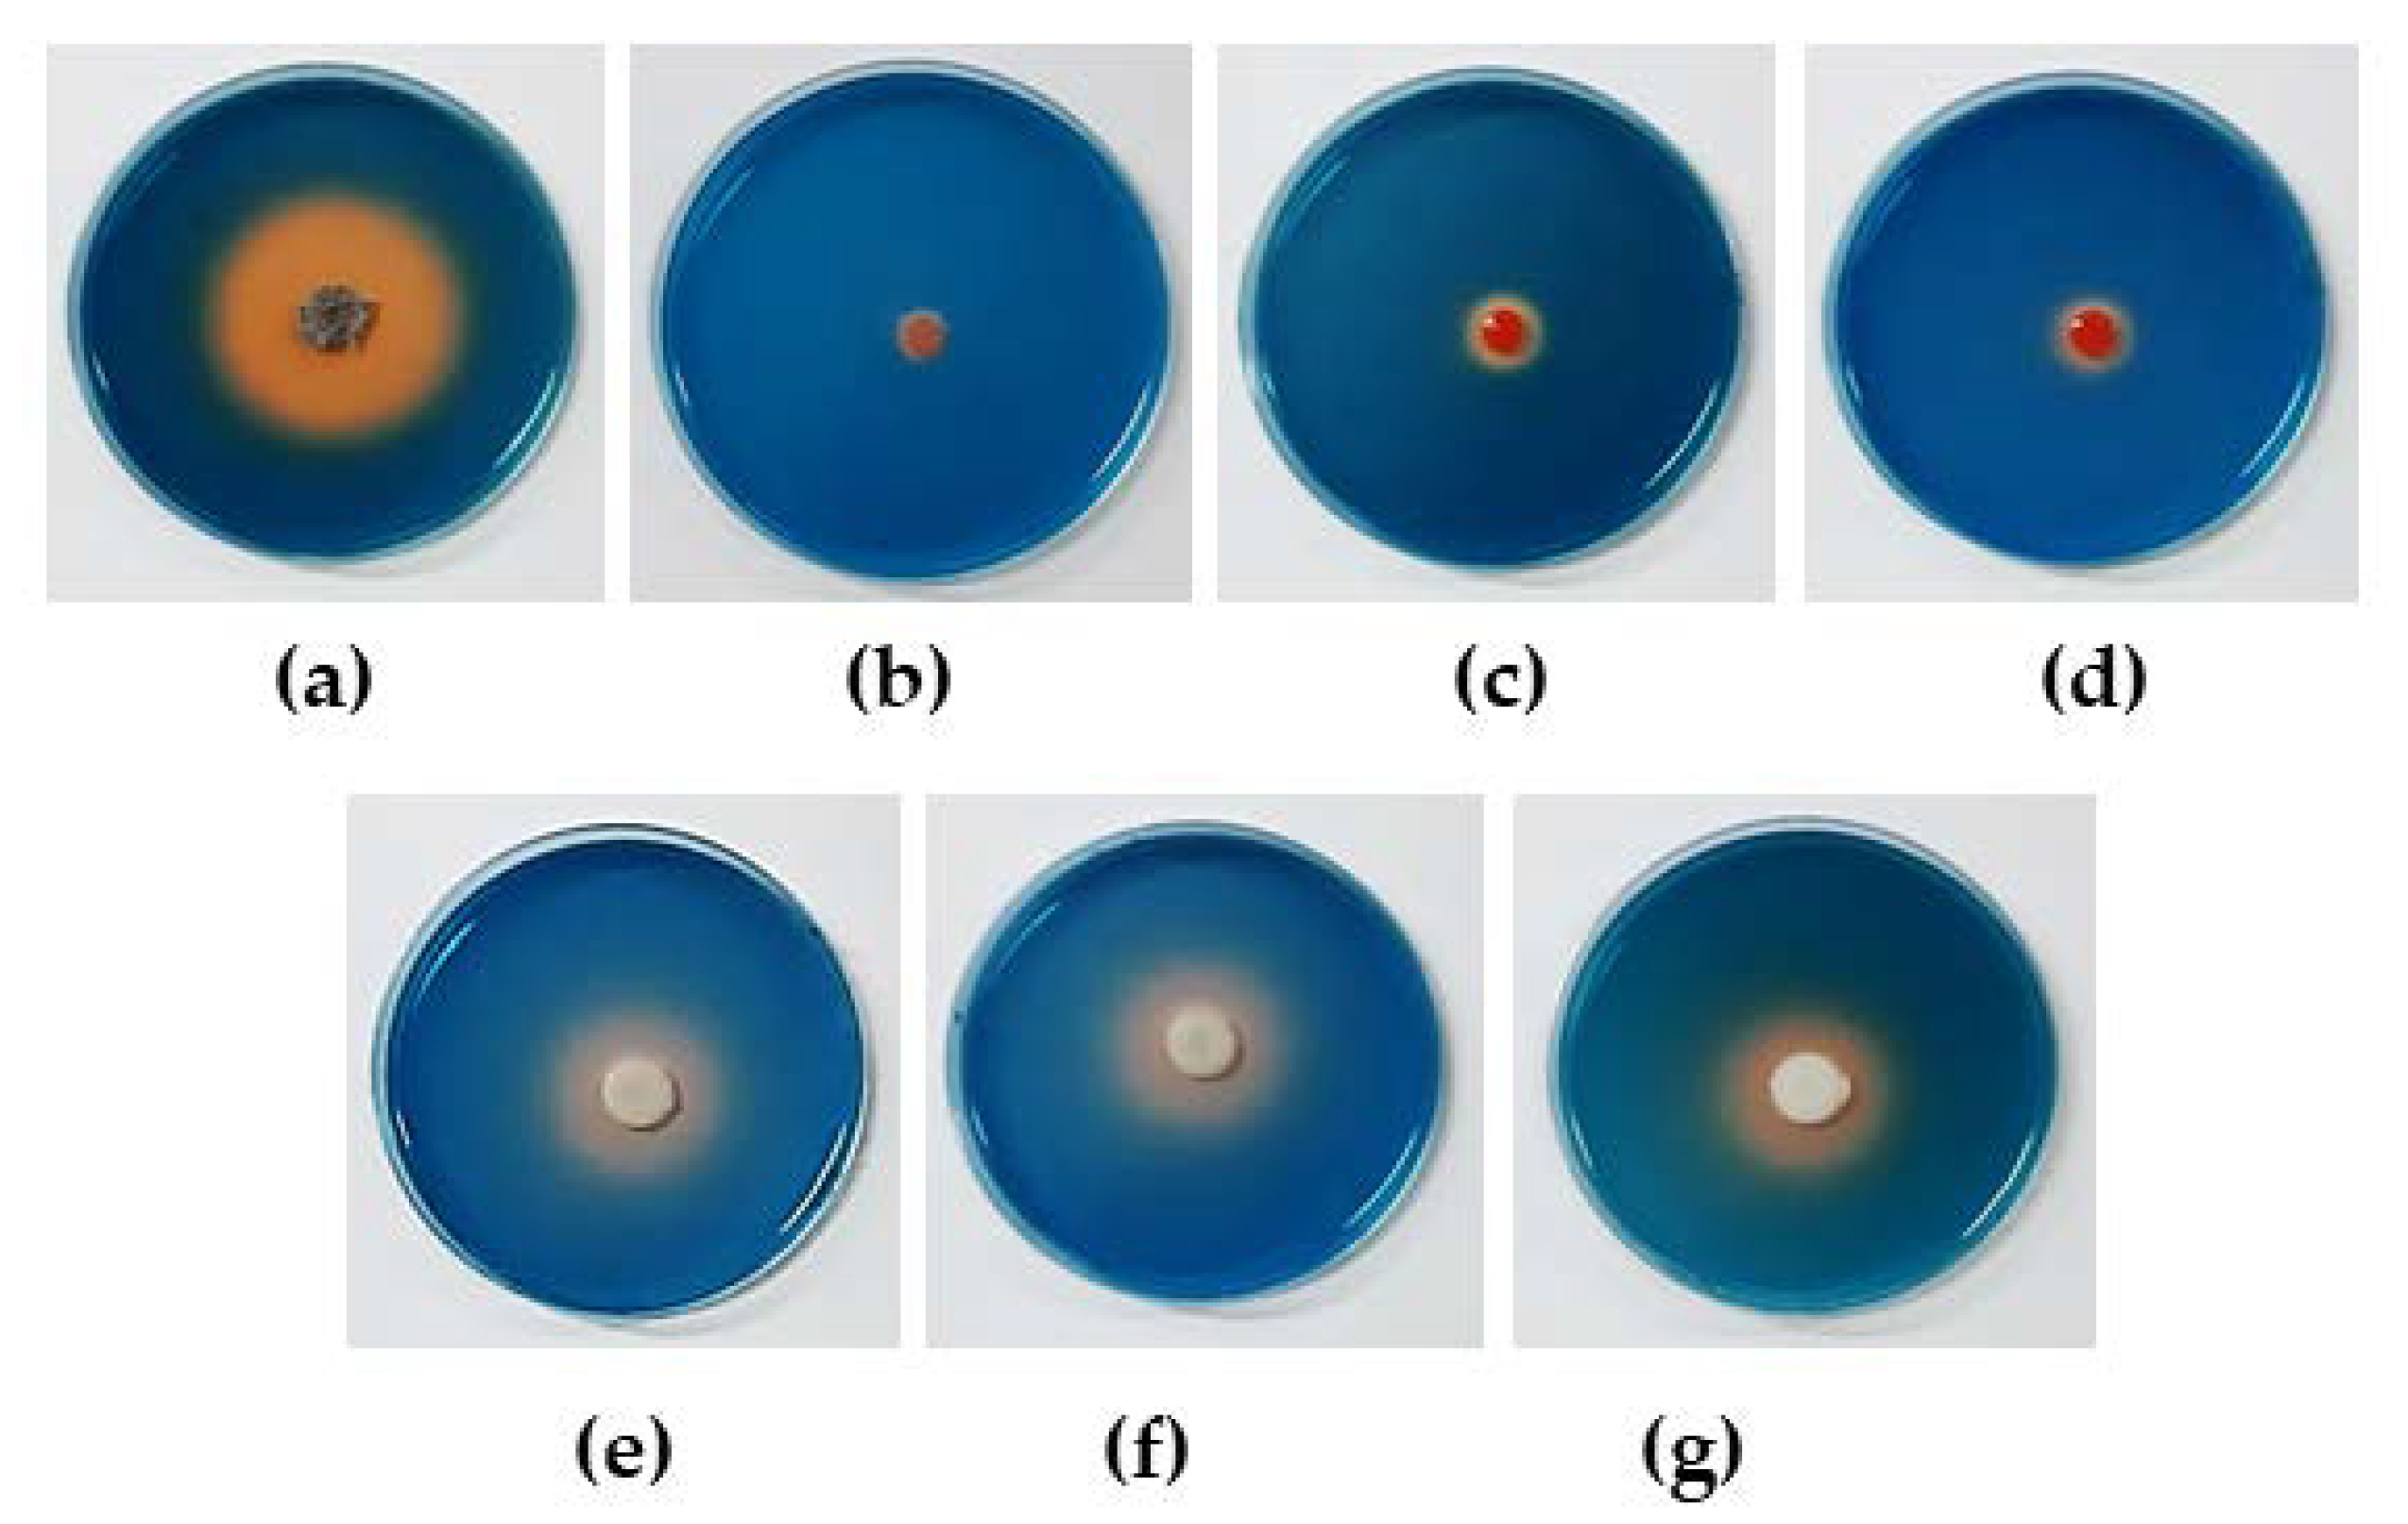
Microorganisms 08 00647 g003 Microorganisms 08 00647 g003

Biocontrol of Rice Seedling Rot Disease Caused by Curvularia lunata and Helminthosporium oryzae by Epiphytic Yeasts from Plant Leaves
Abstract
1. Introduction
2. Materials and Methods
2.1. Epiphytic Yeasts
2.2. Fungal Pathogens
2.3. Evaluation In Vitro of Antagonistic Activities of Epiphytic Yeasts against Fungal Pathogens Causing Rice Seedling Rot Disease
2.4. Evaluation of Antagonistic Mechanisms of Antagonistic Yeasts
2.4.1. Production of Antifungal Volatile Organic Compounds (VOCs)
2.4.2. Competition for Nutrients
2.4.3. Production of β-Glucanase and Chitinase
2.4.4. Biofilm Formation
2.4.5. Siderophore Production
2.4.6. Phosphate and Zinc Oxide Solubilization
2.5. Evaluation of the Efficacy of Antagonistic Yeasts in Controlling Rice Seedling Rot Disease in a Greenhouse
- Seed germination (%) = (number of germinated seeds/total number of seeds planted) × 100
- Seedling vigor index (SVI) (%) = (stem height + root length) × seed germination (%)
- Disease incidence (%) = [(SVI of negative control − SVI of positive control or treatment)/SVI of negative control] × 100
- Disease control (%) = [(disease incidence of positive control − disease incidence of each treatment)/disease incidence in positive control] × 100
2.6. Statistical Analysis
3. Results
3.1. Evaluation in Vitro of Antagonistic Activities of Epiphytic Yeasts against Fungal Pathogens Causing Rice Seedling Rot Disease
3.2. Evaluation of Antagonistic Mechanisms of Antagonistic Yeasts
3.2.1. Production of Antifungal Volatile Organic Compounds (VOCs)
3.2.2. Production of β-Glucanase and Chitinase
3.2.3. Biofilm Formation
3.2.4. Siderophore Production
3.2.5. Phosphate and Zinc Oxide Solubilization
3.3. Evaluation of the Control of Rice Seedling Rot Disease in a Greenhouse
4. Discussion
Supplementary Materials
Author Contributions
Funding
Conflicts of Interest
References
- Plodpai, P.; Chuenchitt, S.; Petcharat, V.; Chakthong, S.; Voravuthikunchai, S.P. Anti-Rhizoctonia solani activity by Desmos chinensis extracts and its mechanism of action. Crop. Prot. 2012, 43, 65–71. [Google Scholar]
- Rice Department, Ministry of Agriculture and Cooperatives of Thailand. Seedling Rot Disease in Nursery Box. 2014. Available online: http://www.ricethailand.go.th/rkb3/title-index.php-file=content.php&id=131-1.htm (accessed on 20 January 2020).
- Imolehin, E. Rice seed borne fungi and their effect on seed germination. Plant Dis. 1983, 67, 1334–1336. [Google Scholar]
- Ibaraki, T. Diseases of rice seedlings growing in the nursery box. JARQ 1988, 21, 251–256. [Google Scholar]
- Kong, C.; Xu, X.; Zhang, M.; Zhang, S. Allelochemical tricin in rice hull and its aurone isomer against rice seedling rot disease. Pest Manag. Sci. 2010, 66, 1018–1024. [Google Scholar]
- Ito, S.; Tokunaga, Y. Studies on the rot-disease of rice-seedlings caused by Pythium-species. J. Fac. Agric. Hokkaido Imp. Univ. 1933, 32, 201–228. [Google Scholar]
- Verma, S.; Kingsley, K.; Bergen, M.; Kowalski, K.; White, J. Fungal disease prevention in seedlings of rice (Oryza sativa) and other grasses by growth-promoting seed-associated endophytic bacteria from invasive Phragmites australis. Microorganisms 2018, 6, 21. [Google Scholar]
- Adachi, N.; Tsukamoto, S.; Inoue, Y.; Azegami, K. Control of bacterial seedling rot and seedling blight of rice by bacteriophage. Plant Dis. 2012, 96, 1033–1036. [Google Scholar]
- Williamson, M.; Fokkema, N. Phyllosphere yeasts antagonize penetration from appressoria and subsequent infection of maize leaves by Colletotrichum graminicola. Eur. J. Plant Pathol. 1985, 91, 265–276. [Google Scholar]
- Adams, P. The potential of mycoparasites for biological control of plant pathogens. Annu. Rev. Phytopathol. 1990, 28, 59–72. [Google Scholar]
- Adhikari, T.; Joseph, C.; Yang, G.; Phillips, D.; Nelson, L. Evaluation of bacteria isolated from rice for plant growth promotion and biological control of seedling disease of rice. Can. J. Microbiol. 2001, 47, 916–924. [Google Scholar]
- Khalili, E.; Sadravi, M.; Naeimi, S.; Khosravi, V. Biological control of rice brown spot with native isolates of three Trichoderma species. Braz. J. Microbiol. 2012, 43, 297–305. [Google Scholar]
- Into, P.; Khunnamwong, P.; Jindamoragot, S.; Am-in, S.; Intanoo, W.; Limtong, S. Yeast associated with rice phylloplane and their contribution to control of rice sheath blight disease. Microorganisms 2020, 8, 362. [Google Scholar]
- Khunnamwong, P.; Lertwattanasakul, N.; Jindamorakot, S.; Suwannarach, N.; Matsui, K.; Limtong, S. Evaluation of antagonistic activity and mechanisms of endophytic yeasts against pathogenic fungi causing economic crop diseases. Folia Microbiol. 2019, 1–18. [Google Scholar] [CrossRef]
- Konsue, W.; Dethoup, T.; Limtong, S. Biological control of fruit rot and anthracnose of postharvest mango by antagonistic yeasts from economic crops leaves. Microorganisms 2020, 8, 317. [Google Scholar]
- Chincholkar, S.; Mukerji, K.; Chandrashekara, C.; Chakravarthi, M. Biological Control of Plant Diseases. In Eco-Friendly Innovative Approaches in Plant Disease Management; Singh, V.K., Singh, Y., Singh, A., Eds.; International Book Distributors: Dehradun, India, 2012; pp. 147–166. [Google Scholar]
- Spadaro, D.; Gullino, M. Improving the efficacy of biocontrol agents against soilborne pathogens. Crop. Prot. 2005, 24, 601–613. [Google Scholar]
- Elsharkawya, M.M.; Nakatanib, M.; Nishimurab, M.; Arakawab, T.; Shimizub, M.; Hyakumachib, M. Suppression of rice blast, cabbage black leaf spot, and tomato bacterial wilt diseases by Meyerozyma guilliermondii TA-2 and the nature of protection. Acta Agric. Scand. Sect. B Plant Soil Sci. 2015, 65, 629–636. [Google Scholar]
- Kunyosying, D.; To-anun, C.; Cheewangkoon, R. Control of rice blast disease using antagonistic yeasts. Int. J. Agric. Technol. 2018, 14, 83–98. [Google Scholar]
- Matić, S.; Spadaro, D.; Garibaldi, A.; Gullino, M. Antagonistic yeasts and thermotherapy as seed treatments to control Fusarium fujikuroi on rice. Biol. Control 2014, 73, 59–67. [Google Scholar]
- Rosa, M.; Tauk-Tornisielo, S.; Rampazzo, P.; Ceccato-Antonini, S. Evaluation of the biological control by the yeast Torulaspora globosa against Colletotrichum sublineolum in sorghum. World J. Microbiol. Biotechnol. 2010, 26, 1491–1502. [Google Scholar]
- Di Francesco, A.; Ugolini, L.; Lazzeri, L.; Mari, M. Production of volatile organic compounds by Aureobasidium pullulans as a potential mechanism of action against postharvest fruit pathogens. Biol. Control 2015, 81, 8–14. [Google Scholar]
- Zhang, D.; Spadaro, D.; Garibaldi, A.; Gullino, M. Efficacy of the antagonist Aureobasidium pullulans PL5 against postharvest pathogens of peach, apple and plum and its modes of action. Biol. Control 2010, 54, 172–180. [Google Scholar] [CrossRef]
- Miller, G. Use of dinitrosalicylic acid reagent for determination of reducing sugar. Anal. Chem. 1959, 31, 426–429. [Google Scholar] [CrossRef]
- Růžička, F.; Holá, V.; Votava, M.; Tekkalov, R. Importance of biofilm in Candida parapsilosis and evaluation of its susceptibility to antifungal agents by colorimetric method. Folia Microbiol. 2007, 52, 209–214. [Google Scholar] [CrossRef]
- Stepanović, S.; Vuković, D.; Hola, V.; Bonaventura, G.; Djukić, S.; Ćirković, I.; Ruzicka, F. Quantification of biofilm in microtiter plates: Overview of testing conditions and practical recommendations for assessment of biofilm production by staphylococci. APMIS 2007, 115, 891–899. [Google Scholar] [CrossRef]
- Schwyn, B.; Neilands, J. Universal chemical assay for the detection and determination of siderophores. Anal. Biochem. 1987, 160, 47–56. [Google Scholar] [CrossRef]
- Zaidi, S.; Usmani, S.; Singh, B.; Musarrat, J. Significance of Bacillus subtilis strain SJ-101 as a bioinoculant for concurrent plant growth promotion and nickel accumulation in Brassica juncea. Chemosphere 2006, 64, 991–997. [Google Scholar] [CrossRef]
- Rokhbakhsh-Zamin, F.; Sachdev, D.; Kazemi-Pour, N.; Engineer, A.; Pardesi, K.; Zinjarde, S.; Dhakephalkar, P.; Chopade, B. Characterization of plant-growth-promoting traits of Acinetobacter species isolated from rhizosphere of Pennisetum glaucum. J. Microbiol. Biotechnol. 2011, 21, 556–566. [Google Scholar]
- Hashem, M.; Alamri, S.; Hesham, A.; Al-Qahtani, F.; Kilany, M. Biocontrol of apple blue mould by new yeast strains: Cryptococcus albidus KKUY0017 and Wickerhamomyces anomalus KKUY0051 and their mode of action. Biocontrol Sci. Technol. 2014, 24, 1137–1152. [Google Scholar] [CrossRef]
- Oro, L.; Feliziani, E.; Ciania, M.; Romanazzib, G.; Comitinia, F. Volatile organic compounds from Wickerhamomyces anomalus, Metschnikowia pulcherrima and Saccharomyces cerevisiae inhibit growth of decay causing fungi and control postharvest diseases of strawberries. Int. J. Food Microbiol. 2018, 265, 18–22. [Google Scholar] [CrossRef]
- Ou, C.; Liu, Y.; Wang, W.; Dong, D. Integration of UV-C with antagonistic yeast treatment for controlling post-harvest disease and maintaining fruit quality of Ananas comosus. BioControl 2016, 61, 591–603. [Google Scholar] [CrossRef]
- Jaibangyang, S.; Nasanit, R.; Limtong, S. Biological control of aflatoxin-producing Aspergillus flavus by volatile organic compound-producing antagonistic yeasts. BioControl 2020, 1–10. [Google Scholar] [CrossRef]
- Sukmawati, D.; Andrianto, M.; Arman, Z.; Ratnaningtyas, N.; Al Husna, S.; El-Enshasy, H.; Dailin, D.; Kenawy, A. Antagonistic activity of phylloplane yeasts from Moringa oleifera Lam. leaves against Aspergillus flavus UNJCC F-30 from chicken feed. Indian Phytopathol. 2020, 73, 79–88. [Google Scholar] [CrossRef]
- Zhang, H.; Yang, Q.; Lin, H.; Ren, X.; Zhao, L.; Hou, J. Phytic acid enhances biocontrol efficacy of Rhodotorula mucilaginosa against postharvest gray mold spoilage and natural spoilage of strawberries. LWT-Food Sci. Technol. 2013, 52, 110–115. [Google Scholar] [CrossRef]
- Cheng, Z.; Mengshan, C.; Guangkun, L.; Huizhen, C.; Yuan, S.; Hanjv, S.; Michael, W.; Yongsheng, L.; Jia, L. Heat shock improves stress tolerance and biocontrol performance of Rhodotorula mucilaginosa. Biol. Control. 2016, 95, 49–56. [Google Scholar] [CrossRef]
- Ando, H.; Hatanaka, K.; Ohata, I.; Yamashita-Kitaguchi, Y.; Kurata, A.; Kishimoto, N. Antifungal activities of volatile substances generated by yeast isolated from Iranian commercial cheese. Food Control 2012, 26, 472–478. [Google Scholar] [CrossRef]
- Hua, S.; Beck, J.; Sarreal, S.; Gee, W. The major volatile compound 2-phenylethanol from the biocontrol yeast, Pichia anomala, inhibits growth and expression of aflatoxin biosynthetic genes of Aspergillus flavus. Mycotoxin Res. 2014, 30, 71–78. [Google Scholar] [CrossRef]
- Huang, R.; Li, G.; Zhang, J.; Yang, L.; Che, H.; Jiang, D.; Huang, H. Control of postharvest Botrytis fruit rot of strawberry by volatile organic compounds of Candida intermedia. Phytopathology 2011, 101, 859–869. [Google Scholar] [CrossRef]
- Zhou, Y.; Li, W.; Zeng, J.; Shao, Y. Mechanisms of action of the yeast Debaryomyces nepalensis for control of the pathogen Colletotrichum gloeosporioides in mango fruit. Biol. Control 2018, 123, 111–119. [Google Scholar] [CrossRef]
- Tian, Y.; Li, W.; Jiang, Z.; Jing, M.; Shao, Y. The preservation effect of Metschnikowia pulcherrima yeast on anthracnose of postharvest mango fruits and the possible mechanism. Food Sci. Biotechnol. 2018, 27, 95–105. [Google Scholar] [CrossRef]
- Droby, S.; Wisniewski, M.; Macarisin, D.; Wilson, C. Twenty years of postharvest biocontrol research: Is it time for a new paradigm? Postharvest Biol. Technol. 2009, 52, 137–145. [Google Scholar] [CrossRef]
- Parafati, L.; Vitale, A.; Restuccia, C.; Cirvilleri, G. Biocontrol ability and action mechanism of food-isolated yeast strains against Botrytis cinerea causing post-harvest bunch rot of table grape. Food Microbiol. 2015, 47, 85–92. [Google Scholar] [CrossRef] [PubMed]
- Giobbe, S.; Marceddu, S.; Scherm, B.; Zara, G.; Mazzarello, V.; Budroni, M.; Migheli, Q. The strange case of a biofilm-forming strain of Pichia fermentans, which controls Monilinia brown rot on apple but is pathogenic on peach fruit. FEMS Yeast Res. 2007, 7, 1389–1398. [Google Scholar] [CrossRef] [PubMed]
- Lima, J.; Gondim, D.; Oliveira, J.; Oliveira, F.; Gonçalves, L.; Viana, F. Use of killer yeast in the management of postharvest papaya anthracnose. Postharvest Biol. Technol. 2013, 83, 58–64. [Google Scholar] [CrossRef]
- Zhang, D.; Spadaro, D.; Garibaldi, A.; Gullino, M.L. Potential biocontrol activity of a strain of Pichia guilliermondii against grey mold of apples and its possible modes of action. Biol. Control 2011, 57, 193–201. [Google Scholar] [CrossRef]
- Zepeda-Giraud, L.; Olicón-Hernandez, D.; Martínez-López, C.; Guerra-Sánchez, G. Study of the action mode of Wickerhamomyces anomalus against Colletotrichum gloeosporioides. J. Agric. Sci. Technol. 2016, 6, 341–349. [Google Scholar]
- Spadaro, D.; Droby, S. Development of biocontrol products for postharvest diseases of fruit: The importance of elucidating the mechanisms of action of yeast antagonists. Trends Food Sci. Technol. 2016, 47, 39–49. [Google Scholar] [CrossRef]
- Sansone, G.; Rezza, I.; Calvente, V.; Benuzzi, D.; de Tosetti, M. Control of Botrytis cinerea strains resistant to iprodione in apple with rhodotorulic acid and yeasts. Postharvest Biol. Technol. 2005, 35, 245–251. [Google Scholar] [CrossRef]
- Olanrewaju, O.; Glick, B.; Babalola, O. Mechanisms of action of plant growth promoting bacteria. World J. Microbiol. Biotechnol. 2017, 33, 197. [Google Scholar] [CrossRef]
- Nutaratat, P.; Srisuk, N.; Arunrattiyakorn, P.; Limtong, S. Plant growth-promoting traits of epiphytic and endophytic yeasts isolated from rice and sugar cane leaves in Thailand. Fungal Biol. 2014, 118, 683–694. [Google Scholar] [CrossRef]
- Boukaew, S.; Chanasirin, K.; Poonsuk, P. Potential for the integration of biological and chemical control of sheath blight disease caused by Rhizoctonia solani on rice. World J. Microbiol. Biotechnol. 2013, 29, 1885–1893. [Google Scholar] [CrossRef]
- Groth, D.; Bond, J. Effects of cultivars and fungicides on rice sheath blight, yield, and quality. Plant Dis. 2007, 91, 1647–1650. [Google Scholar] [CrossRef] [PubMed]
- Nandakumar, R.; Babu, S.; Viswanathan, R.; Raguchander, T.; Samiyappan, R. Induction of systemic resistance in rice against sheath blight disease by Pseudomonas fluorescens. Soil Biol. Biochem. 2001, 33, 603–612. [Google Scholar] [CrossRef]
- Rush, M.C.; Schneider, R.W. Chemical Control of Seedling Diseases of Rice in Louisiana. In Pest Management in Rice; Grayson, B.T., Green, M.B., Copping, L.G., Eds.; Springer: Dordrecht, The Netherlands, 1990; pp. 53–70. [Google Scholar]
- Webster, R.K.; Hall, D.H.; Bostad, J.; Wick, C.M.; Brandon, D.M.; Baskett, R.; Williams, J.M. Chemical seed treatment for the control of seedling disease of water-sown rice. Hilgardia 1973, 41, 689–698. [Google Scholar] [CrossRef][Green Version]
- Anitha, S.; Savitha, G. Impact of mancozeb stress on seedling growth, seed germination, chlorophyll and phenolic contents of rice cultivars. IJSR 2013, 4, 292–296. [Google Scholar]

| Fungal Pathogen and Yeast | Growth Inhibition by VOCs (%) 1 | Growth Inhibition on PDA with Different Nutrient Concentration 2 | |||
|---|---|---|---|---|---|
| A 3 | B 4 | C 5 | D 6 | ||
| Curvularia lunata DOAC 2313 with | |||||
| Candida tropicalis YE-111 | 20.1 ± 1.4c | 45.9 ± 2.4a | 25.2 ± 2.0b | 0c | 0c |
| Hannaella sinensis DMKU-CP437 | 14.3 ± 1.6f | 45.4 ± 1.3a | 17.1 ± 1.3b | 0c | 0c |
| Hannaella sinensis YE-19 | 17.4 ± 0.8de | 44.8 ± 0.6a | 17.9 ± 0.7b | 0c | 0c |
| Hannaella sinensis YE-58 | 5.5 ± 2.2h | 49.3 ± 0.2a | 21.8 ± 1.6b | 0c | 0c |
| Papiliotrema japonica YE-135 | 4.2 ± 0.8h | 43.6 ± 1.9a | 20.1 ± 1.6 | 0c | 0c |
| Rhodotorula mucilaginosa YE-171 | 10.4 ± 0.9g | 45.1 ± 2.0a | 19.4 ± 1.0b | 0c | 0c |
| Rhodotorula taiwanensis YE-9 | 32.1 ± 1.0b | 45.6 ± 1.9a | 17.4 ± 0.8b | 0c | 0c |
| Rhodotorula taiwanensis YE-213 | 31.8 ± 1.0b | 48.4 ± 0.5a | 19.0 ± 5.6 | 0c | 0c |
| Wickerhamomyces anomalus DMKU-CP122 | 19.8 ± 0.9cd | 48.1 ± 1.4a | 21.2 ± 1.1b | 6.1 ± 1.2c | 0d |
| Wickerhamomyces anomalus DMKU-CP127 | 15.3 ± 1.4ef | 43.5 ± 3.0a | 22.0 ± 1.2b | 3.0 ± 1.8c | 0d |
| Wickerhamomyces anomalus YE-42 | 48.9 ± 0.8a | 51.2 ± 1.6a | 35.2 ± 1.3b | 0c | 0c |
| Helminthosporium oryzae DOAC 2293 with | |||||
| Candida michaelii YE-239 | 12.6 ± 0.8b | 39.6 ± 1.9a | 20.9 ± 0.8b | 5.7 ± 1.4c | 0d |
| Hannaella sinensis YE-19 | 1.0 ± 1.2d | 51.2 ± 1.4a | 39.1 ± 1.1b | 18.2 ± 0.9c | 2.3 ± 2.4d |
| Hannaella sinensis YE-58 | 0.7 ± 1.3d | 49.0 ± 3.5a | 23.7 ± 0.7b | 7.5 ± 2.1c | 0d |
| Hannaella hubeiensis YE-21 | 11.0 ± 0.2bc | 39.2 ± 1.8a | 21.1 ± 1.1b | 11.9 ± 1.8c | 0d |
| Rhodotorula mucilaginosa YE-171 | 9.3 ± 1.0c | 49.7 ± 2.5a | 26.8 ± 1.8b | 7.0 ± 1.4c | 0.5 ± 1.4d |
| Wickerhamomyces anomalus YE-42 | 25.1 ± 1.0a | 40.0 ± 1.2a | 22.0 ± 1.8b | 17.1 ± 0.7c | 0d |
| Yeast | Enzyme Activities (mU/mL) | |
|---|---|---|
| Glucanase | Chitinase | |
| Candida michaelii YE-239 | 62.6 ± 0.8 | 6.0 ± 18.3 |
| Candida tropicalis YE-111 | 102.4 ± 3.0 | 16.9 ± 29.5 |
| Hannaella sinensis DMKU-CP437 | 0.2 ± 0.0 | 35.2 ± 3.5 |
| Hannaella sinensis YE-19 | 8.5 ± 3.1 | 3.8 ± 3.8 |
| Hannaella sinensis YE-58 | 0.2 ± 0.5 | 0 |
| Papiliotrema japonica YE-135 | 112.9 ± 0.8 | 504.5 ± 148.4 |
| Pseudozyma hubiensis YE-21 | 27.5 ± 1.8 | 0 |
| Rhodotorula mucilaginosa YE-171 | 116.5 ± 1.9 | 173.4 ± 17.7 |
| Rhodotorula taiwanensis YE-9 | 58.9 ± 1.5 | 1.0 ± 3.2 |
| Rhodotorula taiwanensis YE-213 | 0 | 0 |
| Wickerhamomyces anomalus DMKU-CP122 | 30.3 ± 4.5 | 45.2 ± 1.8 |
| Wickerhamomyces anomalus DMKU-CP127 | 0 | 0 |
| Wickerhamomyces anomalus YE-42 | 48.9 ± 3.5 | 0 |
| Yeast | Biofilm formation | Siderophore Production 4 | SE e | |||
|---|---|---|---|---|---|---|
| ODT 1 | OD Value 2 | Sum 3 | Ca3(PO)4 | ZnO | ||
| Candida michaelii YE-239 | 0.0973 ± 0.0023 | 1.68 | weak | 0 | 0 | 0 |
| Candida tropicalis YE-111 | 0.3025 ± 0.0085 | 5.21 | strong | 0 | 0 | 0 |
| Hannaella sinensis DMKU-CP437 | 0.2296 ± 0.0141 | 3.96 | moderate | 0 | 0 | 0 |
| Hannaella sinensis YE-19 | 0.2054 ± 0.0096 | 3.54 | moderate | 0 | 0 | 0 |
| Hannaella sinensis YE-58 | 0.2130 ± 0.0133 | 3.67 | moderate | 0 | 0 | 0 |
| Papiliotrema japonica YE-135 | 0.1263 ± 0.0026 | 2.18 | moderate | 0 | 0 | 0 |
| Pseudozyma hubiensis YE-21 | 0.1155 ± 0.0065 | 1.99 | weak | 46.5 ± 1.2 | 0 | 0 |
| Rhodotorula mucilaginosa YE-171 | 0.3586 ± 0.0194 | 6.18 | weak | 9.1 ± 0.2 | 0 | 0 |
| Rhodotorula taiwanensis YE-9 | 0.2389 ± 0.0060 | 4.12 | weak | 15.5 ± 0.5 | 0 | 0 |
| Rhodotorula taiwanensis YE-213 | 0.2062 ± 0.0130 | 3.56 | moderate | 14.1 ± 0.1 | 0 | 0 |
| Wickerhamomyces anomalus DMKU-CP122 | 0.1831 ± 0.0156 | 3.16 | moderate | 32.8 ± 1.1 | 1.3 ± 0.1 | 1.3 ± 0.0 |
| Wickerhamomyces anomalus DMKU-CP127 | 0.1331 ± 0.0057 | 2.29 | moderate | 32.4 ± 1.6 | 1.4 ± 0.0 | 1.3 ± 0.0 |
| Wickerhamomyces anomalus YE-42 | 0.2143 ± 0.0058 | 3.69 | moderate | 34.5 ± 0.6 | 1.5 ± 0.1 | 1.4 ± 0.1 |
| Treatment | Stem (cm) | Root (cm) | Dry Weight (g) 2 | Seed Germination (%) | Seedling Vigor Index | Disease Incidence (%) | Disease Control (%) |
|---|---|---|---|---|---|---|---|
| Negative control | 51.87 ± 6.75abc | 10.70 ± 4.22cd | 120.09 ± 6.63abc | 89.00 ± 2.45a | 5569.73 ± 218.38a | - | - |
| Positive control: Curvularia lunata DOAC 2313 alone | 46.02 ± 7.17i | 8.48 ± 3.49e | 71.73 ± 7.25d | 71.00 ± 4.90gh | 3869.67 ± 177.95g | 30.52 | - |
| Curvularia lunata DOAC 2313 with | |||||||
| Candida tropicalis YE-111 | 47.86 ± 6.88h | 11.01 ± 3.92bcd | 86.19 ± 11.34d | 77.67 ± 4.19cdefg | 4572.33 ± 325.00ef | 17.91 | 41.33 |
| Hannaella sinensis YE-19 | 49.27 ± 7.18efg | 12.01 ± 4.52a | 110.55 ± 7.88abc | 83.00 ± 3.27abcde | 5085.67 ± 226.99abcde | 8.69 | 71.52 |
| Hannaella sinensis YE-58 | 49.65 ± 6.87ef | 11.31 ± 4.08abcd | 105.28 ± 8.00bc | 75.33 ± 3.40efg | 4592.33 ± 242.28def | 17.55 | 42.50 |
| Hannaella sinensis DMKU-CP437 | 50.91 ± 5.85cd | 11.32 ± 4.15abcd | 84.68 ± 10.29d | 74.67 ± 3.68fg | 4646.67 ± 289.27cdef | 16.57 | 45.70 |
| Kodamaea ohmeri DMKU-RP06 1 | 50.37 ± 6.23de | 11.54 ± 3.98abc | 104.89 ± 6.62bc | 81.67 ± 3.40abcdef | 5055.67 ± 166.01abcde | 9.23 | 69.76 |
| Kodamaea ohmeri DMKU-RP57 1 | 51.65 ± 6.04abc | 11.00 ± 4.03bcd | 102.30 ± 5.70c | 82.33 ± 3.68abcdef | 5158.33 ± 233.27abcde | 7.39 | 75.80 |
| Kodamaea ohmeri DMKU-RP233 1 | 51.44 ± 5.86abcd | 11.34 ± 3.83abc | 116.72 ± 4.35abc | 86.33 ± 2.87ab | 5419.33 ± 172.56a | 2.70 | 91.15 |
| Meyerozyma caribbica DMKU-RP07 1 | 52.23 ± 6.34ab | 11.15 ± 4.27abcd | 114.81 ± 2.93abc | 83.00 ± 2.16abcdef | 5259.37 ± 147.95abc | 5.57 | 81.74 |
| Papiliotrema japonica YE-135 | 52.10 ± 5.21abc | 10.99 ± 3.77bcd | 109.54 ± 3.67abc | 81.00 ± 1.63abcdef | 5110.00 ± 25.66abcde | 8.25 | 72.96 |
| Rhodotorula mucilaginosa YE-171 | 51.20 ± 6.82bcd | 10.85 ± 3.68cd | 116.82 ± 11.73abc | 85.67 ± 3.68abc | 5316.00 ± 250.50ab | 4.56 | 85.07 |
| Rhodotorula taiwanensis YE-9 | 48.16 ± 7.25gh | 10.44 ± 4.16d | 84.76 ± 5.02d | 75.67 ± 4.92defg | 4434.00 ± 326.70f | 20.39 | 33.19 |
| Rhodotorula taiwanensis YE-213 | 48.58 ± 6.81fgh | 11.58 ± 4.02abc | 82.95 ± 7.59d | 78.67 ± 3.30bcdefg | 4733.70 ± 232.82bcdef | 15.02 | 50.78 |
| Torulaspora indica DMKU-RP31 1 | 52.18 ± 4.87abc | 11.16 ± 4.05abcd | 122.91 ± 8.80ab | 88.33 ± 2.49a | 5595.00 ± 302.03a | 0 | 100 |
| Torulaspora indica DMKU-RP35 1 | 52.24 ± 5.25ab | 10.84 ± 3.75cd | 114.63 ± 3.07abc | 83.67 ± 2.49abcde | 5277.67 ± 179.00ab | 5.24 | 82.82 |
| Wickerhamomyces anomalus DMKU-CP122 | 51.98 ± 5.44abc | 11.43 ± 3.93abc | 105.23 ± 8.43bc | 82.00 ± 4.55abcdef | 5199.67 ± 472.67abcd | 6.64 | 78.23 |
| Wickerhamomyces anomalus DMKU-CP127 | 52.52 ± 5.00a | 11.43 ± 4.42abc | 115.15 ± 3.52abc | 83.67 ± 3.30abcde | 5350.33 ± 358.39ab | 3.94 | 87.09 |
| Wickerhamomyces anomalus DMKU-RP04 1 | 52.48 ± 4.90ab | 11.12 ± 3.91bcd | 115.81 ± 2.15abc | 85.67 ± 4.99abc | 5448.67 ± 349.44a | 2.17 | 92.88 |
| Wickerhamomyces anomalus DMKU-RP25 1 | 51.47 ± 5.98abcd | 11.20 ± 3.99abcd | 112.51 ± 11.4abc | 84.00 ± 2.16abcd | 5264.33 ± 172.62abc | 5.48 | 82.03 |
| Wickerhamomyces anomalus YE-42 | 52.45 ± 4.60ab | 11.26 ± 3.84abcd | 121.52 ± 10.59ab | 88.67 ± 2.87a | 5649.00 ± 338.01a | 0 | 100 |
| Carbendazim® | 52.61 ± 5.55a | 11.84 ± 4.13ab | 127.73 ± 4.54a | 81.00 ± 2.94abcdef | 5220.67 ± 239.98abc | 6.27 | 79.47 |
| Mancozeb® | 48.78 ± 6.55fgh | 11.10 ± 4.67bcd | 79.94 ± 12.34d | 64.67 ± 3.68h | 3872.33 ± 183.03g | 30.48 | 0.15 |
| Treatment | Stem (cm) | Root (cm) | Dry Weight (g) 2 | Seed Germination (%) | Seedling Vigor Index | Disease Incidence (%) | Disease Control (%) |
|---|---|---|---|---|---|---|---|
| Negative control | 51.87 ± 6.75a | 10.70 ± 4.22d | 120.09 ± 6.63ab | 89.00 ± 2.45a | 5544.00 ± 209.93ab | nd | nd |
| Positive control: Helminthosporium oryzae DOAC 2293 alone | 45.84 ± 6.95d | 8.53 ± 3.56e | 82.57 ± 3.31e | 76.00 ± 1.63e | 4132.00 ± 120.78e | 25.47 | nd |
| Helminthosporium oryzae oryzae DOAC 2293 with | |||||||
| Candida michaelii YE-239 | 52.44 ± 5.47a | 12.15 ± 8.12a | 103.56 ± 1.40cd | 81.33 ± 1.70bcde | 5253.67 ± 97.04bc | 5.24 | 79.44 |
| Hannaella sinensis YE-19 | 49.07 ± 6.17c | 10.52 ± 3.95d | 95.27 ± 2.14d | 80.00 ± 2.16cde | 4766.67 ± 88.21d | 14.02 | 44.95 |
| Hannaella sinensis YE-58 | 52.38 ± 4.46a | 11.25 ± 4.07bcd | 94.47 ± 1.41d | 79.00 ± 2.16de | 5027.00 ± 92.61cd | 9.33 | 63.37 |
| Meyerozyma caribbica DMKU-RP55 1 | 52.06 ± 6.15a | 11.03 ± 4.30bcd | 101.86 ± 3.84d | 82.33 ± 2.87bcd | 5195.00 ± 194.37bc | 6.30 | 75.27 |
| Pseudozyma hubiensis YE-21 | 50.72 ± 6.05b | 10.78 ± 4.03cd | 105.60 ± 0.84cd | 86.67 ± 2.49ab | 5330.33 ± 209.48abc | 3.85 | 84.88 |
| Rhodotorula mucilaginosa YE-171 | 52.35 ± 5.27a | 10.92 ± 3.68bcd | 94.97 ± 2.12d | 78.67 ± 2.87de | 4977.33 ± 142.64cd | 10.22 | 59.87 |
| Torulaspora indica DMKU-RP31 1 | 52.24 ± 4.95a | 11.08 ± 4.06bcd | 123.22 ± 0.58ab | 90.33 ± 0.94a | 5719.33 ± 120.63a | 0 | 100 |
| Torulaspora indica DMKU-RP35 1 | 52.37 ± 5.17a | 10.94 ± 3.83bcd | 117.15 ± 3.36ab | 87.00 ± 2.94ab | 5508.00 ± 247.92ab | 0.65 | 97.45 |
| Wickerhamomyces anomalus DMKU-RP04 1 | 52.26 ± 4.94a | 10.77 ± 3.92cd | 118.11 ± 3.99ab | 88.33 ± 2.05a | 5567.33 ± 200.73ab | 0 | 100 |
| Wickerhamomyces anomalus DMKU-RP25 1 | 51.75 ± 5.62a | 11.27 ± 4.14bcd | 109.58 ± 3.27bc | 85.00 ± 1.63abc | 5357.33 ± 121.26abc | 3.37 | 86.77 |
| Wickerhamomyces anomalus YE-42 | 52.39 ± 4.82a | 11.65 ± 4.24abc | 121.85 ± 7.20ab | 89.00 ± 1.41a | 5699.33 ± 189.84a | 0 | 100 |
| Carbendazim® | 52.59 ± 5.57a | 11.85 ± 4.06ab | 127.73 ± 4.54a | 84.67 ± 3.68abc | 5445.67 ± 238.94ab | 1.77 | 94.04 |
| Mancozeb® | 48.83 ± 6.51c | 11.22 ± 4.61bcd | 79.94 ± 8.34e | 69.67 ± 4.11f | 4175.92 ± 265.19e | 24.69 | 3.05 |
© 2020 by the authors. Licensee MDPI, Basel, Switzerland. This article is an open access article distributed under the terms and conditions of the Creative Commons Attribution (CC BY) license (http://creativecommons.org/licenses/by/4.0/).
Share and Cite
Limtong, S.; Into, P.; Attarat, P. Biocontrol of Rice Seedling Rot Disease Caused by Curvularia lunata and Helminthosporium oryzae by Epiphytic Yeasts from Plant Leaves. Microorganisms 2020, 8, 647. https://doi.org/10.3390/microorganisms8050647
Limtong S, Into P, Attarat P. Biocontrol of Rice Seedling Rot Disease Caused by Curvularia lunata and Helminthosporium oryzae by Epiphytic Yeasts from Plant Leaves. Microorganisms. 2020; 8(5):647. https://doi.org/10.3390/microorganisms8050647
Chicago/Turabian StyleLimtong, Savitree, Parichat Into, and Panchapond Attarat. 2020. "Biocontrol of Rice Seedling Rot Disease Caused by Curvularia lunata and Helminthosporium oryzae by Epiphytic Yeasts from Plant Leaves" Microorganisms 8, no. 5: 647. https://doi.org/10.3390/microorganisms8050647
APA StyleLimtong, S., Into, P., & Attarat, P. (2020). Biocontrol of Rice Seedling Rot Disease Caused by Curvularia lunata and Helminthosporium oryzae by Epiphytic Yeasts from Plant Leaves. Microorganisms, 8(5), 647. https://doi.org/10.3390/microorganisms8050647

